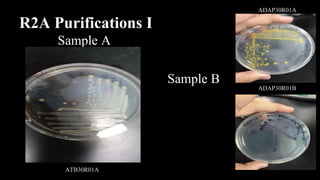
R2A Purifications I
Sample A
Sample B
ADAP30R01A
ADAP30R01B
ATB30R01A
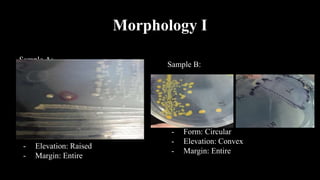
Morphology I
Sample A:
- Form: Circular
- Elevation: Raised
- Margin: Entire
Sample B:
- Form: Circular
- Elevation: Convex
- Margin: Entire
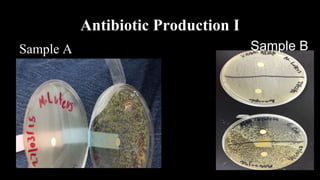
Antibiotic Production I
Sample A Sample B

The document summarizes soil bacteria isolation and characterization from four tropical soil samples (A-D) collected in Puerto Rico. Samples were analyzed for humidity, temperature, pH and GPS coordinates at collection sites. Gram staining showed samples A-B and C-D contained gram-positive bacteria. Morphology analysis found all samples contained circular bacteria that varied in elevation and margin characteristics. PCR and electrophoresis identified bacteria in samples A-B but not C-D. Purification isolated bacteria from samples A-B in R2A medium and from samples C-D in ISP4 and LB media. Antibiotic production testing and electrophoresis were also performed.